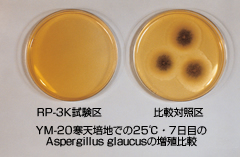
Photo: mold prevention(with RP-K and without RP-K)

Preservation of Cultural Assets
RP System is applicable for museums, galleries, libraries, archives, cultural properties and so on. It does not require large-scale equipment for gas-fumigation but a heat-sealing machine only.
AIR-G, Automatic Relative Humidity Controlled Nitrogen Generator is available. It is to treat big cultural properties, up to approx. 3m3. For further Information, please ask your distributor.
RP-K type agent for non-metallic artifacts.
RP-K type absorbs oxygen and corrosive gas but not moisture. RP-K is to treat and to preserve nonmetallic cultural properties such as wood, paper, fabric, leather and so on. It is effective in insect proof and dust control of physical objects.
Please refer to the products list.

※Important Notice:Do not use RP Agent type K with excess air volume, for example less number of agents, improper seal and / or pinholes. It may cause of undesired organic acid generation.
ESCAL / an MGC exclusive high gas-barrier film.
ESCAL has higher gas-barrier characteristics than MGC's PTS film.
Supplied in tubes of three different width allows for the accomodation of various size artifacts: long and short. ESCAL is endless tube form and has a data entry white strip along the edge.

ESCAL film is a roll form of film. For the preservation of large cultural assets, containers can be created to match the object. This requires an electric clip sealer to make hermetically seals.

Please refer to the products list page about size /lot specifications of the above product.
Oxygen indicators
An Oxygen indicator is to show the presence or absence of oxygen in sealed container by change of color. The blue color changes to pink as the atmospheric oxygen content becomes 0.1% or less.
This is used to check the initial effect of the RP System. Regarding detailed information, please contact us before use.
 |
|
|
Presence of O2 |
Absence of O2 |
Other attributes using RP-K type agent.
As insecticide
It is known that eggs and larvae, pupae and imagos, will perish within two weeks under anaerobic conditions at room temperature. Under these conditions, eggs place inside the wooden ware will be killed. As this method adds nothing to the artifact, it is much easier and safer method than fumigation with insecticides.
- eg. Artifacts made of wood, cloth, leather, paper or any combination of the aforemen- tioned materials.
Mold prevention
Any aerobic microbe including mold does not propagate under oxygen-free conditions.
- Aplication examples: products made of paper, textiles, wood and leather
|
|
|
With RP-K |
Without RP-K |
Prevention of Oxidation
Prevents the yellowing of paper due to aging.
aterpoofing cultural assets
Once cultural assets are sealed in Escal bags, the assets are not only protected from moisture and humidity but also flooding in case of a disaster.
Biocidal Product Regulation in EU
MGC's Oxygen Absorbers are not intended to be used for the following purposes in EU.
- Preservation of food against insects
- Preservation of cultural assets against insects and mildew and mold growth.
For more detail, please refer to the following document.
Inquiries Concerning Products
Mitsubishi Gas Chemical Trading, Inc.
Specialty Materials Group
Specialty Materials Div.
Chemicals BU
TEL:+81-3-6626-3362
